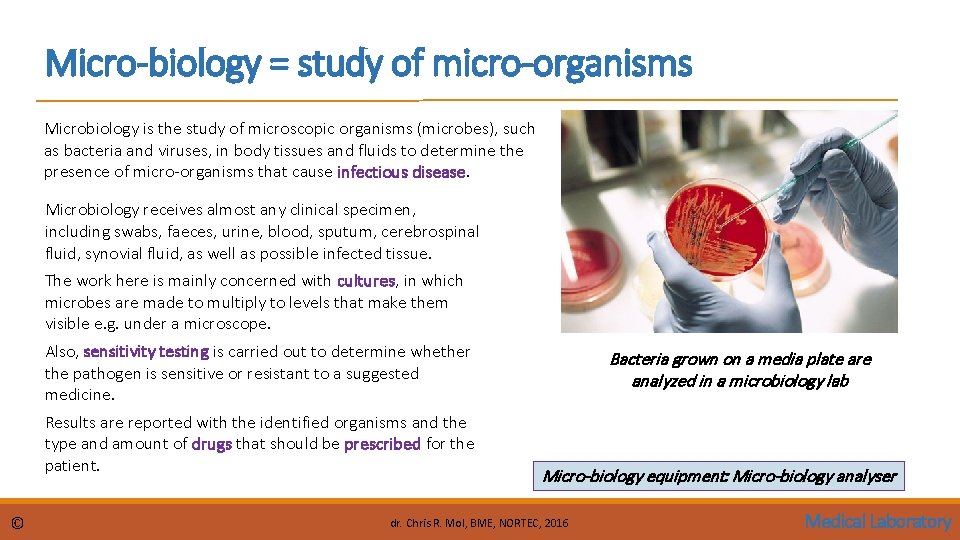
Micro-biology = study of micro-organisms Microbiology is the study of microscopic organisms (microbes), such

Identify areas of a Medical Laboratory o Intro

Identify areas of a Medical Laboratory o Intro o Blood p. H, haematocrit, haemoglobin, WBCs, RBCs, platelets o Electrolytes and metabolites o Microbiological organisms o Specialties o Quality control in the lab o Quality assurance in the lab 18. 7. 1 Identify areas of a medical laboratory Unit C 18. 7 Maintaining Laboratory Equipment Module 279 19 C Medical Instrumentation II © dr. Chris R. Mol, BME, NORTEC, 2016

Medical Laboratory A medical (or clinical) laboratory is responsible for analysing patient specimens to obtain information to aid in the diagnosis of disease and evaluate the effectiveness of therapy. Because many critical patient-care decisions are based on test results supplied by the clinical laboratory, the accuracy and precision of these results are of great importance. A fast report of Lab results is often important since critical patient decisions can depend on this. A Pathologist is a specialized medical doctor working in the clinical Lab. © Medical Labs may also be private organizations and located outside hospitals, providing services for primary physicians. dr. Chris R. Mol, BME, NORTEC, 2016 Medical Laboratory

Work Flow in a Medical Lab • Sample processing will usually start with a set of samples and a request form. • Typically a set of vacutainer tubes containing blood, or any other specimen, will arrive to the laboratory in a small plastic bag, along with the form. • The form and the specimens are given a laboratory number, often as a sticker that can be placed on the tubes and form. This label has a barcode that can be scanned by automated analyzers. • For biochemistry samples, blood is usually centrifuged and serum (plasma) is separated. If the serum needs to go on more than one machine, it can be divided into separate tubes. • Many specimens end up in one or more sophisticated automated analysers, that process a fraction of the sample and return one or more "results". • The work flow in a lab is usually heavy from 2: 00 am to 10: 00 am, so that results are available for all patients during the morning round of the doctors (also in Zambia ? ). © dr. Chris R. Mol, BME, NORTEC, 2016 Vacutainer Tubes sterile, vacuum filled tube facilitating the draw of a liquid. They may contain additives designed to preserve the specimen prior to analytical testing. Medical Laboratory

Trend: Automation The medical lab has involved from performing tests that required a lot of manual handling of patient samples into fully automatic analysis equipment. This has increased the safety of the personnel working in the lab, the speed of analysis (lab throughput) as well as improved the reliability of the outcome of the analysis. © dr. Chris R. Mol, BME, NORTEC, 2016 Medical Laboratory

In the following slides some physiological aspects related to the most common lab measurements are discussed. This relates to your Physiology and Anatomy lectures in year 1 and the Medical Instrumentation I lectures at the start of year 2. • Blood • Electrolytes and metabolites • Microbiological organisms © dr. Chris R. Mol, BME, NORTEC, 2016 Medical Laboratory

Blood is a body fluid that delivers necessary substances such as nutrients and oxygen to the cells and transports metabolic waste products away from those same cells. When it reaches the lungs, gas exchange occurs: carbon dioxide is diffused out of the blood into the pulmonary alveoli and oxygen is diffused into the blood. An adult person contains about 5 litres of blood. It is bright red when its hemoglobin is oxygenated and dark red when it is de-oxygenated. Human blood is composed of blood cells suspended in blood plasma. • blood plasma: is mostly water, plus proteins, glucose, mineral ions, hormones and • blood cells: red blood cells, white blood cells and platelets. Red blood cells contain hemoglobin, an iron-containing protein, which facilitates oxygen transport. Hematology is the study of blood in health and disease. A hematologist is a medical doctor who treats patients with blood disease. © dr. Chris R. Mol, BME, NORTEC, 2016 Medical Laboratory

Blood measurements in the lab p. H is a measure of the concentration of the hydrogen ion (H+) in an aqueous solution. Solutions with a p. H less than 7 are said to be acidic and solutions with a p. H greater than 7 are basic or alkaline. Pure water has a p. H of 7. In humans, a normal p. H of most tissues and fluids of the body (except the stomach, p. H=1) is slightly alkaline. The most critical p. H is in the blood. All other organs and fluids will fluctuate in their range in order to keep the blood a strict p. H between 7. 35 and 7. 45 (slightly alkaline). Haematocrit (Ht, HCT) is the volume percentage (%) of red blood cells in blood. It is normally 45% for men and 40% for women. It is one of the factors that determine the blood’s capability to deliver oxygen. Anemia refers to an abnormally low haematocrit, With modern lab equipment, the haematocrit is measured by an automated analyser. © dr. Chris R. Mol, BME, NORTEC, 2016 Medical Laboratory

Blood measurements in the lab Hemoglobin (Hgb or Hb) is a protein molecule and the main component in red blood cells that transports oxygen in the blood. A typical normal value is 15 gm/d. L. Red Blood Cells (RBCs), also called erythrocytes, are the most common type of blood cells. A RBC count is a lab test which measures the number of red blood cells per blood volume. A normal RBC count is around 5 million cells per microliter of blood. White Blood Cells (WBCs), also called leukocytes, are the cells of the immune system that are involved in protecting the body against both infectious disease and foreign invaders. A WBC count is a lab test which measures the number of white blood cells per blood volume. A normal WBC count is 7, 500 white blood cells per microliter of blood. Separation of blood cells in centrifuge Platelets, also called thrombocytes, are important to stop bleeding by clumping and clotting blood vessel injuries. A normal platelet count ranges from 150, 000 to 450, 000 platelets per microliter of blood. © dr. Chris R. Mol, BME, NORTEC, 2016 Medical Laboratory

Complete Blood Count In requesting lab analysis of a blood sample (patient), multiple tests for specific blood components (such as a glucose test or a cholesterol test) are often grouped together into one test panel called a blood panel or blood work. A Complete Blood Count (CBC), or Full Blood Count (FBC), is a blood panel that gives an overview of the cells in a patient's blood, such as the cell count for each cell type and the concentrations of various proteins and minerals. © dr. Chris R. Mol, BME, NORTEC, 2016 Medical Laboratory

Electrolytes are minerals in blood and other body fluids that carry an electric charge. An electrolyte ionizes (breaks up in ions) when dissolved in solvents such as water. Na. Cl(s) → Na+(aq) + Cl−(aq) Electrolytes affect the amount of water in your body, the p. H of blood, signal conduction along nerves, muscle function, etc. An electrolyte panel is a blood test that measures the levels of electrolytes and carbon dioxide (CO 2) in your blood. CO 2 is a waste product made when the body breaks down food for energy (metabolism). It helps your blood stay at the right p. H. An electrolyte panel measures the blood levels of carbon dioxide, chloride, potassium, and sodium. © dr. Chris R. Mol, BME, NORTEC, 2016 Medical Laboratory

Metabolites A metabolite is any substance produced during metabolism (digestion or other bodily chemical processes). Metabolites are produced by the cell because they are indispensable for their growth. Examples are amino acids, alcohols, vitamins and organic acids. Metabolites have various functions, such as fuel, structure, signalling, stimulatory and inhibitory effects on enzymes. The Comprehensive Metabolic Panel (CMP) is a frequently and routinely ordered group of 14 tests. The CMP is used as a broad screening tool to check for conditions such as diabetes, liver disease, and kidney disease. © dr. Chris R. Mol, BME, NORTEC, 2015 Medical Laboratory

Organisms & Microbiology There are four kinds of micro-organisms that cause infectious disease: bacteria, fungi, parasites and viruses. Many diseases can already be identified by micro-organisms in body tissues, at a time when patient complaints are not yet present. Often, micro-organisms need to be multiplied/grown before they can be seen and measured. This is done via a ‘culture’ in an environment with selective ‘food’ for the suspected microorganisms. This can take many hours/days in well defined conditions (temperature, humidity, …). A microbiological culture, is a method of multiplying microbial organisms by letting them reproduce in culture media under controlled laboratory conditions. From (macroscopic) visual observation of the culture (shape and size of the ‘colonies’) and/or from microscopic observation the cause of infectious disease can be established. Staining (‘colouring’) can be done to support such analysis. In a blood culture, blood is injected into bottles with culture media. © Over the last 10 -20 year, automation of repetitive tasks is taking place, supported by modern IT technology. At the high end, analysers are being developed that can take over a full analysis from the human observer: Micro-biology analysers. dr. Chris R. Mol, BME, NORTEC, 2016 Medical Laboratory

Lab Specialties Clinical labs may be organized in different sections. The main sections are: 1. 2. 3. 4. Bio-Chemistry Micro-Biology Hematology Histology chemical analysis micro organisms, such as bacteria blood cells (red, white, platelets) tissues (with cells) Different lab sections partly use the same type of patient samples, such as blood, urine, faeces, …. In general, they use different equipment, carrying out different types of analysis. but they also share some general equipment such as microscopes, centrifuges and refrigerators (for storing samples). © dr. Chris R. Mol, BME, NORTEC, 2016 it depends on the local hospital organization whether the clinical lab has different departments and, if so, which ones. Medical Laboratory

Bio-chemistry The Bio-chemistry section of the lab is where chemical analysis of patient samples such as blood, urine, cerebrospinal fluid, etc. is done. This is where historically most of the electronic equipment is located. A number of the techniques here are based on analysing the color of different samples, often after staining. The color gives information on the concentration of chemical substances in a sample. Other techniques used are based on electrical properties of the tissues. These are measured when a sample is brought in contact with specific electrodes. Many ‘analyzers’ have been developed in this domain to automate the various procedures. colors are indicative for content glucometer, based on measurement of electrical properties Bio-Chemistry equipment: Spectrophotometer (incl. flame photometer), centrifuges & incubators, hemoglobin and glucose meter, (immuno-) chemistry analyser, vortex mixer, …. . © dr. Chris R. Mol, BME, NORTEC, 2016 Medical Laboratory
Micro-biology = study of micro-organisms Microbiology is the study of microscopic organisms (microbes), such as bacteria and viruses, in body tissues and fluids to determine the presence of micro-organisms that cause infectious disease. Microbiology receives almost any clinical specimen, including swabs, faeces, urine, blood, sputum, cerebrospinal fluid, synovial fluid, as well as possible infected tissue. The work here is mainly concerned with cultures, in which microbes are made to multiply to levels that make them visible e. g. under a microscope. Also, sensitivity testing is carried out to determine whether the pathogen is sensitive or resistant to a suggested medicine. Results are reported with the identified organisms and the type and amount of drugs that should be prescribed for the patient. © Bacteria grown on a media plate are analyzed in a microbiology lab Micro-biology equipment: Micro-biology analyser dr. Chris R. Mol, BME, NORTEC, 2016 Medical Laboratory

Hematology = study of blood (cells) In hematology, blood is analysed to determine the number and character of blood cells, and test on blood functions such as blood clotting (coagulation). Note that other blood-related analysis is done in other parts of the lab, e. g. biochemical analysis. Hematology may include the blood bank where donated blood is selected, stored and preserved for later use in blood transfusion. At a blood bank, careful testing of the blood must be performed to reduce the risk of transfusion related ‘adverse events’. Routine blood storage is usually 6 weeks max. This involves refrigeration but not freezing. Hematology equipment: Hematology analyser, platelet aggregation analyser © dr. Chris R. Mol, BME, NORTEC, 2016 Medical Laboratory

Histology = study of biological Tissues Histology is the study of the microscopic anatomy of cells and tissues. It is commonly performed by examining cells and tissues under a light microscope or electron microscope. In order to prepare for this, the specimen must be fixed, sectioned (cut into a thin cross section with a microtome), stained, and mounted on a microscope slide. Histopathology, the microscopic study of diseased tissue, is important for the accurate diagnosis of cancer and other diseases. Trained physicians, frequently licensed pathologists, are the personnel who perform histo-pathological examination and provide diagnostic information based on their observations. Histology equipment: Tissue processor, embedding center, staining center, microtome, (microscope), . . © dr. Chris R. Mol, BME, NORTEC, 2016 Medical Laboratory

Quality Control in the lab: Detection & Solving problems Laboratory quality control (QC) is designed to detect, reduce, and correct deficiencies in a laboratory's internal processes in order to improve the quality of the results reported by the laboratory. In QC, lab tests are executed on Quality Control material of which the correct outcomes are known. Laboratory Quality Control Tests are usually run at the beginning of each shift, after an instrument is serviced, when reagent lots are changed, after calibration, whenever patient results seem inappropriate. © dr. Chris R. Mol, BME, NORTEC, 2016 Medical Laboratory

Quality Assurance in the lab: Prevention of Problems Important elements of a quality management system include: • Documentation • Standard Operating Procedures (SOP's) • Quality Control samples • External Quality Assessment Scheme A QA program requires a quality management system which covers all aspects influencing the quality of the lab results. The international standard for the accreditation of medical laboratories is ISO 15189 - Medical laboratories Requirements for quality and competence. © dr. Chris R. Mol, BME, NORTEC, 2016 Medical Laboratory

ISO 15189 - Medical laboratories © dr. Chris R. Mol, BME, NORTEC, 2016 Medical Laboratory

END The creation of this presentation was supported by a grant from THET: see https: //www. thet. org/
- Slides: 21